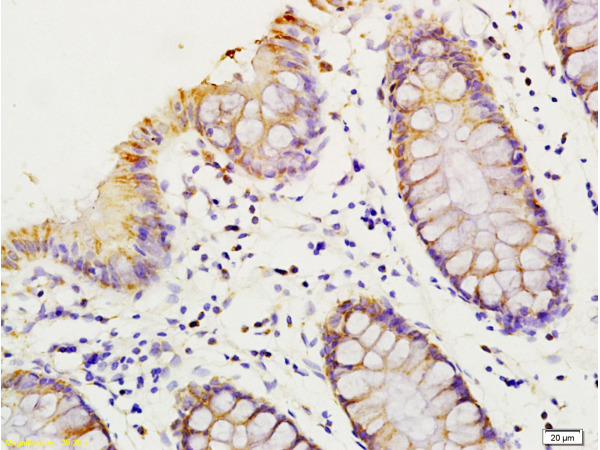

HMGIY / HMGA1 Antibody
LS-C767239
ApplicationsELISA, ImmunoHistoChemistry
Product group Antibodies
ReactivityHuman, Mouse, Rat
TargetHMGA1
Overview
- SupplierLifeSpan BioSciences
- Product NameHMGIY / HMGA1 Antibody
- Delivery Days Customer14
- Application Supplier NoteApplications should be user optimized.
- ApplicationsELISA, ImmunoHistoChemistry
- Applications SupplierELISA (1:2000 - 1:10000), IHC (1:50 - 1:200) Applications should be user optimized.
- CertificationResearch Use Only
- ClonalityPolyclonal
- Concentration0.6 mg/ml
- ConjugateUnconjugated
- Estimated Purity...
- Gene ID3159
- Target nameHMGA1
- Target descriptionhigh mobility group AT-hook 1
- Target synonymsHMG-R, HMGA1A, HMGIY, high mobility group protein HMG-I/HMG-Y, high mobility group protein A1, high mobility group protein R, nonhistone chromosomal high-mobility group protein HMG-I/HMG-Y
- HostRabbit
- IsotypeIgG
- ReactivityHuman, Mouse, Rat
- Storage Instruction-20°C
- UNSPSC12352203